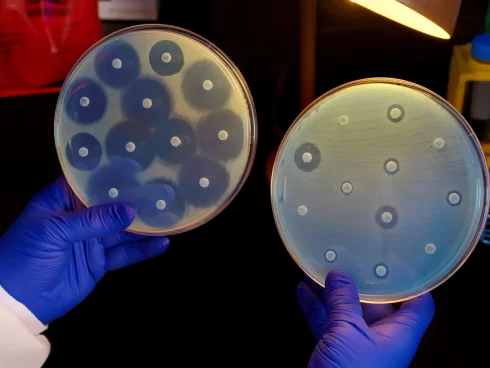

اخبار بیولوژی
مقاومت آنتی بیوتیکی زمانی است که باکتریها توانایی زنده ماندن در معرض آنتی بیوتیکهایی را ایجاد میکنند که برای کشتن آنها یا توقف رشد آنها طراحی شدهاند.
آنتی بیوتیک چیست؟
آنتی بیوتیکها داروهایی هستند که برای درمان یا پیشگیری از عفونتهای ناشی از باکتری استفاده میشوند. آنها در جهت مهار رشد یا از بین بردن باکتریها عمل میکنند. این کار را به روشهای مختلف انجام می دهند، مانند تخریب دیواره و سلول باکتری یا مهار تولید انرژی از گلوکز در سلول باکتری.
مقاومت آنتی بیوتیکی چیست؟
مقاومت آنتیبیوتیکی زمانی رخ میدهد که باکتریها توانایی زنده ماندن در معرض آنتی بیوتیکهایی را ایجاد میکنند که برای کشتن آنها یا توقف رشد آنها طراحی شدهاند. باکتریهای مقاوم به آنتی بیوتیک حتی در صورت قرار گرفتن در معرض آنتی بیوتیکها آزادند که رشد کنند، تکثیر شوند و باعث عفونت در میزبان شوند.
مقاومت آنتی بیوتیکی مانع اصلی در درمان بیماریهای عفونی ناشی از باکتری است. نتیجه این است که آنتی بیوتیکهای خاص دیگر نمیتوانند برای درمان موفقیت آمیز عفونتهای خاص استفاده شوند. این موضوع به طور قابل توجهی بر توانایی ما برای پیشگیری و درمان این بیماری ها، افزایش زمان بهبودی، مدت زمان بستری افراد در بیمارستان و میزان مرگ و میر تأثیر می دارد.
نمونه ای از مقاومت آنتی بیوتیکی که در عکس بالا با روش دیسک دیفیوژن (disk diffusion) نمایان است
درک مکانیسمهایی که توسط آن باکتریها به آنتی بیوتیکها مقاوم میشوند، یک وظیفه کلیدی در جلوگیری از توسعه و گسترش باکتریهای مقاوم به آنتی بیوتیک است. درک این مکانیسمها همچنین در تلاش برای جلوگیری از ایجاد مقاومت باکتریها در برابر درمانهای ضد باکتری جدیدی که ممکن است در آینده تولید شوند، مهم خواهد بود.
مقاومت آنتی بیوتیکی چگونه ایجاد میشود؟
مقاومت آنتیبیوتیکی به دلیل تغییر یا جهش در DNA باکتری یا به دست آوردن ژنهای مقاومت آنتی بیوتیکی از سایر گونههای باکتری از طریق انتقال ژن رخ میدهد.
این تغییرات باکتریها را قادر می سازد تا از اثرات آنتی بیوتیکهایی که برای کشتن آنها طراحی شده اند زنده بمانند. این به این معنی است که وقتی از آنتی بیوتیک استفاده میشود، تمام باکتریهایی که جهش پیدا نکردهاند از بین میروند، در حالی که باکتریهای مقاوم به آنتی بیوتیک بی تاثیر میمانند.
همچنین اخبار مرتبط بخوانید:
ماست حاوی پروبیوتیک از تغییرات میکروبیوم که منجر به اسهال ناشی از آنتی بیوتیک میشود محافظت میکند.
مصرف آنتی بیوتیک ها تا چه حد بر روی ابتلا به سرطان روده بزرگ نقش دارد؟
مقاومت آنتی بیوتیکی ناشی از تداخلات دارویی
باکتریهای مقاوم به آنتی بیوتیک قادر به ادامه تقسیم و رشد هستند و باکتریهای بیشتری تولید میکنند که تحت تأثیر آنتی بیوتیک قرار نمیگیرند. وجود سویههای مقاوم باکتری به این معنی است که آنتی بیوتیکها یا داروهایی که برای از بین بردن آنها طراحی شدهاند، دیگر عمل نمیکنند و به باکتریها اجازه میدهند که به سرعت تکثیر شوند و سلامت عمومی را به خطر بیندازند.
وقتی این اتفاق میافتد، لازم است دانشمندان آنتی بیوتیکهای جدیدی بسازند که باکتریها نسبت به آن مقاومت نداشته باشند.
چرا مقاومت آنتی بیوتیکی بالاست؟
مقاومت آنتی بیوتیکی یک مشکل جدی و رو به رشد در پزشکی مدرن است. استفاده بیش از حد از آنتی بیوتیکها در سالهای اخیر نقش عمدهای در افزایش شیوع باکتریهای مقاوم به آنتی بیوتیک داشته است. با قرار دادن مکرر باکتریها در معرض آنتی بیوتیکها، فشار انتخابی بر باکتریها وارد میکند که احتمال ظهور و گسترش مقاومت را بسیار بیشتر میکند.

تجویز بی رویه آنتی بیوتیک موجب ظهور سوپر باکتری میشود
آنتی بیوتیکها اغلب برای شرایط جزئی تجویز میشوند که به راحتی میتوانند خود به خود بهبود یابند و بیماران اغلب دوره آنتی بیوتیک را طبق تجویز پزشک خود به پایان نمیرسانند زیرا علائم آنها به سرعت بهبود مییابد. برای کمک به جلوگیری از ظهور بیشتر مقاومت آنتیبیوتیکی، اقداماتی انجام میشود تا اطمینان حاصل شود که آنتی بیوتیکها تنها زمانی تجویز میشوند که نیاز آشکار به آنها وجود داشته باشد و به درستی استفاده شوند.

حل نکردن مشکل مقاومت آنتی بیوتیکی موجب 10 میلیون مرگ و میر و 66 تریلیون یورو هزینه تا سال 2050 میشود
مترجم: امید آهنگریان ابهری



